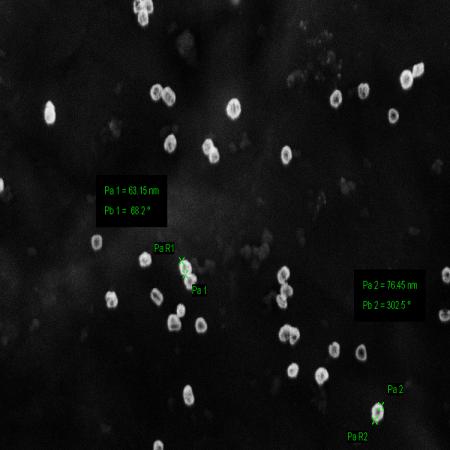
新型纳米材料设计、制备和表征（纳米材料定制服务）

新型纳米材料设计、制备和表征(纳米材料定制服务)
Novel nanomaterials
¥10
1mg
起订
湖北 更新日期:2026-01-19
产品详情:
- 中文名称:
- 新型纳米材料设计、制备和表征(纳米材料定制服务)
- 英文名称:
- Novel nanomaterials
- 品牌:
- LEVIN
- 产品类别:
- 纳米材料
公司简介
来尔文(武汉)生物医药研究院作为生物医药领域研究的科研单位,致力于细胞供应和定制,以及基因产品供应和定制(如质粒)、纳米材料设计和制备、动物模型构建和动物检测、实验技术支持和新药开发等。本单位凭借来尔文(武汉)生物医药研究院的研发实力,拥有多名专业博士、硕士的研发团队,专注于生物产品和生命科学研究的不断完善和创新。为了给科研工作者提供更加便捷服务,单位还同时提供试剂耗材、论文翻译和润色等服务。本着“诚实守信、合作共赢”的理念,来尔文(LEVIN)从创立之初就对接全国所有省市自治区市场,致力为广大科研用户提供专业、高效及优质的产品及服务!
| 成立日期 | (4年) |
| 注册资本 | 100万人民币 |
| 员工人数 | 50-100人 |
| 年营业额 | ¥ 1000万-5000万 |
| 经营模式 | 贸易,工厂,试剂,定制,服务 |
| 主营行业 | 纳米材料,细胞培养,细胞生物学,生物技术服务,整体实验外包服务 |
新型纳米材料设计、制备和表征(纳米材料定制服务)相关厂家报价
-

- 纳米ITO透明导电材料
- 浙江亚美纳米科技有限公司 VIP
- 2026-04-10
- ¥800
-

- 纳米材料专用分散剂 高分散效率 防止纳米颗粒团聚
- 南京保克特新材料有限公司
- 2026-04-09
- ¥190
-

- 透明导电材料纳米ITO粉;纳米氧化铟锡
- 上海杳田新材料科技有限公司 VIP
- 2025-11-22
- ¥1880